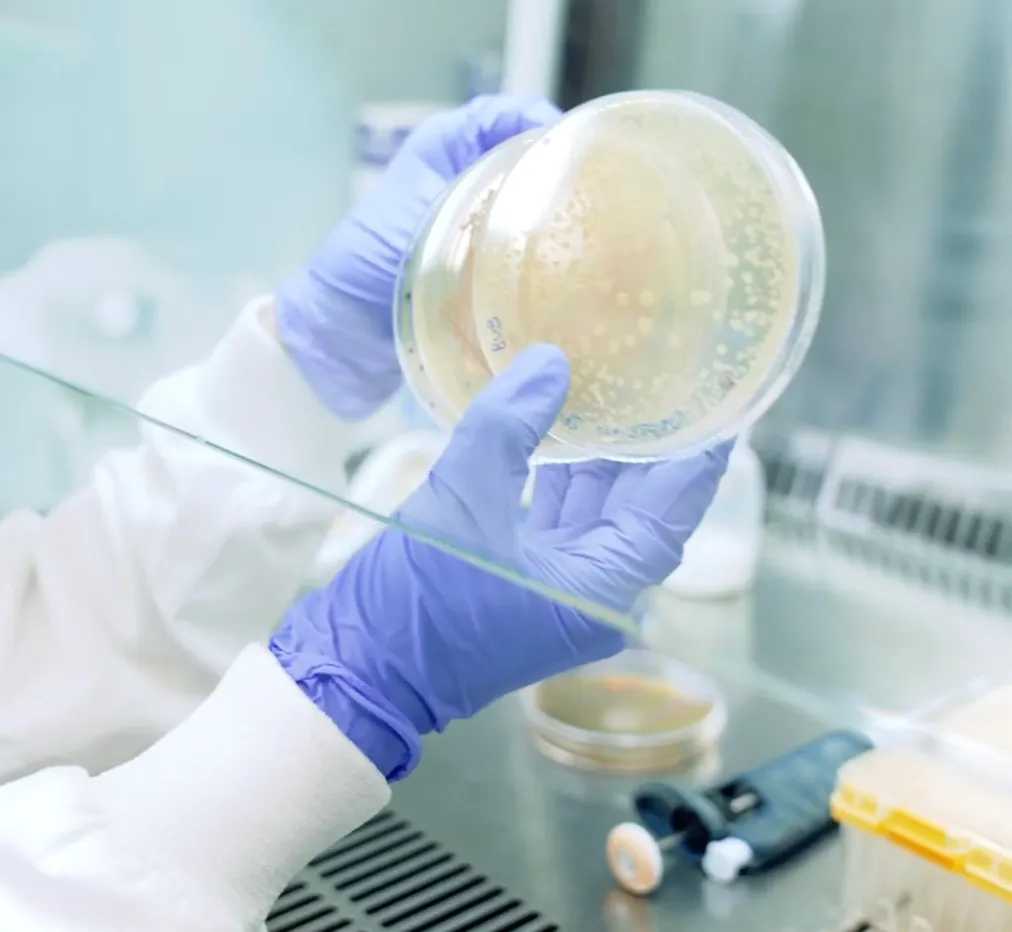
UK Scientists Develop Device to Preserve Breast Milk Microbiome

Sex scandals, fatal errors and missed checks: foreign doctors slip into NHS
The Health Secretary has ordered an urgent review into the vetting of foreign-trained doctors after a Times investigation revealed that medics banned abroad for serious misconduct were able to practise in the NHS. Wes Streeting described the findings as “horrific” and a “serious failure in our medical regulatory systems”, promising that such lapses “will not […]
Sex scandals, fatal errors and missed checks: foreign doctors slip into NHS Read More »